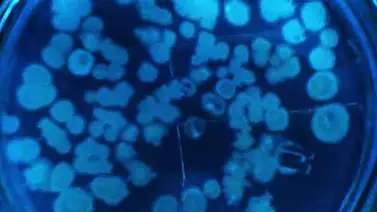
¿Cuál es el ser vivo más pequeño? ¿Cuál es el ser vivo más pequeño?

BBC Mundo
Para vivir independientemente, una bacteria necesita algo de ADN, enzimas para transcribirlo, algunas proteínas para la maquinaria celular y suficientes fluidos para actuar como solvente.
Noticias Relacionadas
Esto requiere una célula de al menos 200 nanómetros (un nanómetro equivale a una mil millonésima de metro) de diámetro.
Hay varias bacterias de este tipo, incluida la Pelagibacter ubique. Cerca del 25% de todas las células del océano son Pelagibacter.
Los virus pueden llegar a medir 80 nanómetros, pero la mayoría de los científicos no los cuentan como seres verdaderamente vivos porque no pueden reproducirse por sí mismos.